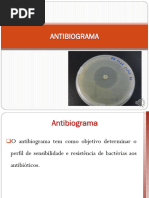

100% acharam este documento útil (1 voto)
575 visualizações42 páginasGuia de Micoses: Coleta e Diagnóstico
1) O documento fornece orientações sobre coleta, processamento e identificação de amostras para diagnóstico de micoses, incluindo recomendações para diferentes tipos de amostras clínicas.
2) São descritos métodos para coleta de amostras de pele, couro cabeludo, unhas, urina, secreções e outros tecidos, bem como instruções para armazenamento e transporte.
3) Também são detalhados procedimentos para processamento das amostras no laboratório e técnicas
Enviado por
SaraKateDireitos autorais
© © All Rights Reserved
Levamos muito a sério os direitos de conteúdo. Se você suspeita que este conteúdo é seu, reivindique-o aqui.
Formatos disponíveis
Baixe no formato PDF, TXT ou leia on-line no Scribd
100% acharam este documento útil (1 voto)
575 visualizações42 páginasGuia de Micoses: Coleta e Diagnóstico
1) O documento fornece orientações sobre coleta, processamento e identificação de amostras para diagnóstico de micoses, incluindo recomendações para diferentes tipos de amostras clínicas.
2) São descritos métodos para coleta de amostras de pele, couro cabeludo, unhas, urina, secreções e outros tecidos, bem como instruções para armazenamento e transporte.
3) Também são detalhados procedimentos para processamento das amostras no laboratório e técnicas
Enviado por
SaraKateDireitos autorais
© © All Rights Reserved
Levamos muito a sério os direitos de conteúdo. Se você suspeita que este conteúdo é seu, reivindique-o aqui.
Formatos disponíveis
Baixe no formato PDF, TXT ou leia on-line no Scribd